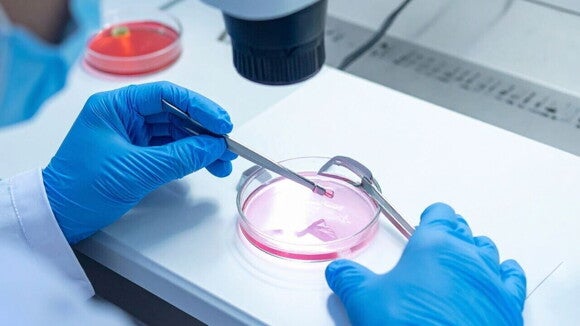
Um técnico de laboratório, usando luvas azuis, manipula um embrião ou material genético em uma placa de Petri com um meio de cultura rosa, utilizando pinças e sob um microscópio.

Congelamento de embriões: entenda o processo, indicações e chances de sucesso
Se você e seu parceiro(a) estão pensando em construir uma família, mas querem planejar o momento ideal para engravidar, o congelamento de embriões pode ser um caminho seguro e cheio de esperança.
O congelamento de embriões é um processo que protege a saúde dos futuros bebês, ajudando a preservar embriões gerados em laboratório, prontos para serem usados quando vocês estiverem preparados.
Quer entender como tudo acontece? Continue lendo o nosso texto para saber tudo sobre o congelamento de embriões.
O que é o congelamento de embriões?
O congelamento de embriões, também chamado de criopreservação, é um procedimento que permite guardar embriões formados em laboratório para o uso futuro.
Após a fertilização in vitro (FIV), os embriões que têm melhor qualidade são selecionados e submetidos à vitrificação, uma técnica que resfria os embriões ultra rapidamente, sem formar cristais de gelo que possam prejudicá-los.
Eles são então armazenados em tanques de nitrogênio líquido a temperaturas muito baixas (cerca de -196 °C), onde ficam preservados com a mesma qualidade e capacidade de desenvolvimento, podendo ser usados quando o casal estiver pronto para tentar a gravidez.
Quando o congelamento de embriões é indicado?
Esse método é indicado para vários casos, como:
- Casais que querem adiar a gravidez, mas preservar a fertilidade para o futuro;
- Mulheres que vão passar por tratamentos médicos (como quimioterapia) que podem afetar a fertilidade;
- Pessoas que desejam aumentar as chances de sucesso em tratamentos de fertilização, congelando embriões excedentes para outras tentativas;
- Situações em que é importante preservar embriões devido a decisões pessoais ou médicas.
Ele oferece uma forma segura de planejar a família no tempo certo, respeitando o momento de cada casal, com respaldo da medicina e da tecnologia.
Veja também: Tratamentos para engravidar: ginecologista explica cada métodos
Quantos anos um embrião pode ficar congelado?
Os embriões podem ser armazenados por tempo indeterminado sem perder sua capacidade de desenvolvimento, desde que sejam mantidos em condições adequadas, com nitrogênio líquido a baixíssimas temperaturas.
Atualmente, não existe um limite máximo de tempo para o congelamento, embriões congelados há muitos anos podem ser usados com chances efetivas de sucesso para iniciar uma gestação.
Como é feito o congelamento de embriões?
O congelamento de embriões começa com a fertilização in vitro, em que a mulher passa por uma estimulação ovariana para gerar vários óvulos, que são coletados e fecundados em laboratório com o esperma do parceiro ou doador.
Os embriões formados são cultivados por alguns dias até atingirem o estágio ideal, geralmente o blastocisto, entre o 5º e 7º dia.
Os embriões de melhor qualidade são preparados para o congelamento usando substâncias crioprotetoras que evitam a formação de cristais de gelo, que podem danificar as células.
A seguir, os embriões são congelados rapidamente (vitrificação) ou lentamente, e armazenados em tanques de nitrogênio líquido a temperaturas ultra baixas, onde permanecem preservados até o momento da utilização.
É ético congelar embriões?
Sim, o congelamento de embriões é considerado ético quando realizado com o consentimento informado dos envolvidos e com acompanhamento médico adequado.
A prática é uma ferramenta que oferece às pessoas e casais o controle sobre seu planejamento familiar, respeitando decisões pessoais e assegurando a preservação de embriões com o máximo cuidado e respeito à vida potencial deles.
Quais as chances de engravidar com embriões congelados?
As chances de gravidez com embriões congelados são bastante animadoras e comparáveis às de embriões frescos. Isso porque a técnica de vitrificação mantém a integridade dos embriões, garantindo alta taxa de sobrevivência no descongelamento e boas chances de implantação no útero.
Variáveis como a idade da mulher no momento da coleta dos óvulos e a qualidade dos embriões influenciam o sucesso das tentativas, mas, de modo geral, o congelamento é uma alternativa eficaz e segura para garantir gravidez futura.
Veja também: O que causa a gestação anembrionada?
Qual é a melhor opção: congelar óvulos ou embriões?
A escolha entre congelar óvulos ou embriões depende do momento da vida e da situação de cada casal. Congelar óvulos é uma opção para mulheres que ainda não têm um parceiro definido ou preferem adiar a decisão da fertilização.
Já congelar embriões pode ser ideal para casais que já realizaram a fertilização e desejam guardar embriões excedentes para futuras tentativas. Embriões congelados têm uma taxa ligeiramente maior de sucesso porque já passaram pela fecundação e seleção de qualidade no laboratório.
Dúvidas frequentes sobre congelamento de embriões
O congelamento prejudica o embrião?
Não, as técnicas modernas como a vitrificação preservam a estrutura e a viabilidade dos embriões.
Posso escolher a hora de usar os embriões?
Sim, os embriões ficam armazenados até que vocês estejam prontos para a transferência.
Existe limite de tempo para o congelamento?
Não há um limite definido, desde que os embriões sejam armazenados corretamente.
O procedimento é doloroso?
O congelamento em si é um processo laboratorial, indolor para a mulher; a coleta dos óvulos pode ter desconforto, mas é rápida e segura.
Quais cuidados devo ter após a transferência?
Seguir as orientações médicas, evitar esforços físicos e ter paciência para o desenvolvimento do embrião.
Veja também: Descolamento ovular: o que é, principais causas e sintomas
Congelamento de embriões: segurança, indicações e expectativas
O congelamento de embriões é uma tecnologia incrível que traz esperança e controle para quem quer planejar a família no momento certo.
Seja para adiar a gravidez, proteger a fertilidade diante de tratamentos médicos ou aumentar as chances de uma gestação, essa técnica preserva os embriões com segurança e carinho, respeitando o tempo e o desejo de cada casal.
Com alta taxa de sucesso e ética respeitada, o congelamento oferece tranquilidade para que vocês possam viver essa jornada com confiança e amor.
As dicas não substituem uma consulta médica. Consulte um profissional de saúde para obter orientações individualizadas.


















